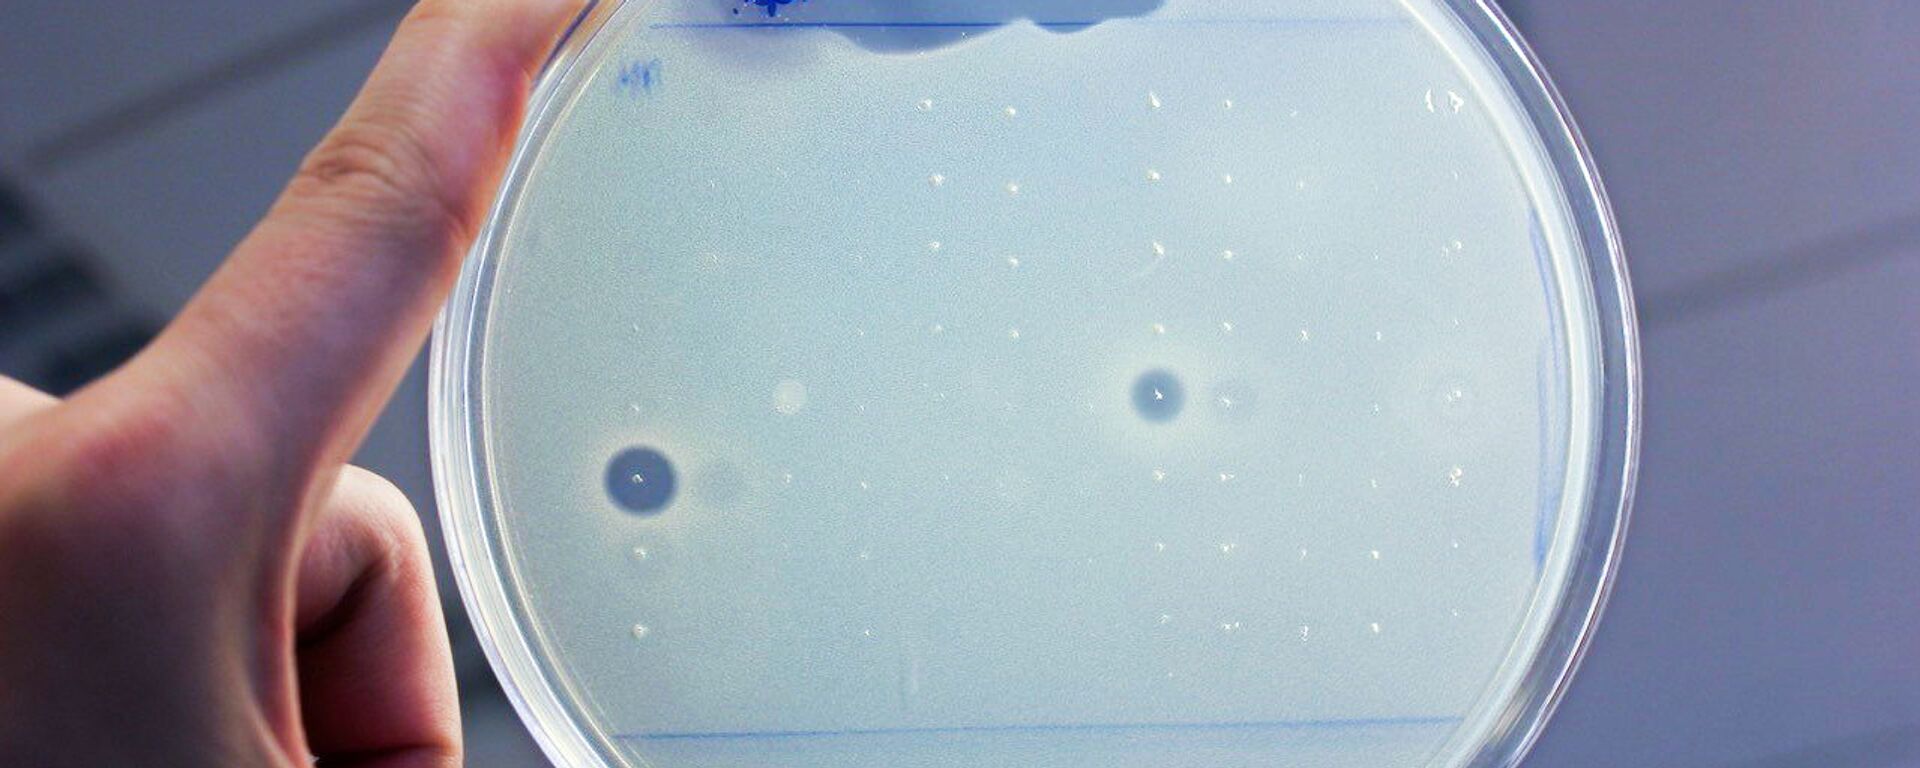
Kháng sinh - Sputnik Việt Nam, 1920, 20.10.2025

https://kevesko.vn/20251030/cac-nha-khoa-hoc-nga-tao-ra-giong-lua-mi-mua-dong-moi-chiu-duoc-thoi-tiet-khac-nghiet-va-benh-tat-39260745.html
Các nhà khoa học Nga tạo ra giống lúa mì mùa đông mới chịu được thời tiết khắc nghiệt và bệnh tật
Các nhà khoa học Nga tạo ra giống lúa mì mùa đông mới chịu được thời tiết khắc nghiệt và bệnh tật
Sputnik Việt Nam
Các nhà lai tạo của Đại học RUDN đã tạo ra một giống lúa mì mềm mùa đông mới "Pobeda 80" có khả năng chống chịu điều kiện thời tiết khắc nghiệt, có sức đề... 30.10.2025, Sputnik Việt Nam
2025-10-30T18:06+0700
2025-10-30T18:06+0700
2025-10-30T18:06+0700
khoa học
nhà khoa học
nga
lúa mì
nông nghiệp
https://cdn.img.kevesko.vn/img/07e7/09/12/25339990_78:0:3719:2048_1920x0_80_0_0_632e114badbecb193898d2b0472f8750.jpg
Theo thông tin từ trường đại học, giống lúa mì này sẽ được sử dụng để sản xuất bột làm bánh mì tại khu vực kinh tế trung tâm thuộc Vùng Đất Không Đen của Nga.Đây là một trong những giống lúa mì phổ biến nhất trên thế giới Erythrospermum có khả năng chống chịu các yếu tố bất lợi về khí hậu và sinh học phức tạp thường thấy ở Vùng Đất Không Đen, đồng thời có năng suất và chất lượng hạt cao, - ông Valery Burlutsky, một trong những tác giả của giống lúa mì mùa đông mới và là giảng viên cao cấp tại Viện Nông nghiệp và Công nghệ thuộc Đại học Hữu nghị Nhân dân Patrice Lumumba của Nga (Đại học RUDN), cho biết.Theo nhà khoa học, giống lúa mì mới được đặt tên "Pobeda 80" để tôn vinh kỷ niệm 80 năm chiến thắng của nhân dân Liên Xô trong Chiến tranh Vệ quốc Vĩ đại, được phát triển để sản xuất bột mì cho các sản phẩm bánh mì và bánh kẹo.Nhà khoa học giải thích, điều này được thực hiện để khắc phục hậu quả của những tình huống phức tạp (thiên tai, điều kiện khí tượng nông nghiệp bất thường, khó khăn kinh tế), khi nông dân không thể gieo trồng theo lịch trình mùa vụ nông học.Theo kết quả nghiên cứu trong nhiều năm quá trình sản xuất sinh thái giống lúa mì mới tại các vùng Matxcơva, Kaluga, Tula và Oryol, có sử dụng các kỹ thuật nông nghiệp hiện đại, các nhà khoa học báo cáo rằng năng suất đạt tới 120 c/ha.Bông hoa lúa mì có hàm lượng hạt cao—80% hoặc hơn. Khi chín, hạt to, căng mọng, đầy đặn (trọng lượng 1.000 hạt và trọng lượng riêng của hạt cao vì nó chứa nhiều protein và tinh bột, do đó có giá trị dinh dưỡng cao), và đồng đều (các hạt có kích thước và hình dạng đồng đều), theo báo cáo của Đại học RUDN.Giống lúa mì này có đặc điểm là bông hoa lúa mì màu trắng, không râu, không lông và hạt cứng, màu đỏ, trong suốt, đặc trưng của giống lúa mì Erythrospermum. Hạt lúa mì "Pobeda 80" chứa tới 16% protein và tới 30% gluten đàn hồi, chắc. Loại hạt này cho năng suất bánh mì cao. Theo Đại học RUDN, đây là nguyên liệu thô chất lượng cao để sản xuất bánh mì, mì ống và các loại bánh nướng khác.
https://kevesko.vn/20251027/cac-nha-khoa-hoc-nga-tim-ra-cach-lam-sach-nuoc-bang-hat-cay-tech-39187735.html
https://kevesko.vn/20251020/cac-nha-khoa-hoc-nga-tao-ra-mot-loai-khang-sinh-moi-39038454.html
Sputnik Việt Nam
moderator.vn@sputniknews.com
+74956456601
MIA „Rossiya Segodnya“
2025
Sputnik Việt Nam
moderator.vn@sputniknews.com
+74956456601
MIA „Rossiya Segodnya“
tin thời sự
vn_VN
Sputnik Việt Nam
moderator.vn@sputniknews.com
+74956456601
MIA „Rossiya Segodnya“
https://cdn.img.kevesko.vn/img/07e7/09/12/25339990_533:0:3264:2048_1920x0_80_0_0_2f3b4b45cca8cc5527f66956547aab84.jpgSputnik Việt Nam
moderator.vn@sputniknews.com
+74956456601
MIA „Rossiya Segodnya“
khoa học, nhà khoa học, nga, lúa mì, nông nghiệp
khoa học, nhà khoa học, nga, lúa mì, nông nghiệp
Các nhà khoa học Nga tạo ra giống lúa mì mùa đông mới chịu được thời tiết khắc nghiệt và bệnh tật
Các nhà lai tạo của Đại học RUDN đã tạo ra một giống lúa mì mềm mùa đông mới "Pobeda 80" có khả năng chống chịu điều kiện thời tiết khắc nghiệt, có sức đề kháng tự nhiên với các bệnh do nấm và vi khuẩn, chống chịu sâu bệnh và cỏ dại.
Theo thông tin từ trường đại học, giống lúa mì này sẽ được sử dụng để sản xuất bột làm bánh mì tại khu vực kinh tế trung tâm thuộc Vùng Đất Không Đen của Nga.
Đây là một trong những giống lúa mì phổ biến nhất trên thế giới Erythrospermum có khả năng chống chịu các yếu tố bất lợi về khí hậu và sinh học phức tạp thường thấy ở Vùng Đất Không Đen, đồng thời có năng suất và chất lượng hạt cao, - ông Valery Burlutsky, một trong những tác giả của giống
lúa mì mùa đông mới và là giảng viên cao cấp tại Viện Nông nghiệp và Công nghệ thuộc Đại học Hữu nghị Nhân dân Patrice Lumumba của Nga (Đại học RUDN), cho biết.

27 Tháng Mười 2025, 17:10
Theo nhà khoa học, giống lúa mì mới được đặt tên "Pobeda 80" để tôn vinh kỷ niệm 80 năm chiến thắng của nhân dân Liên Xô trong
Chiến tranh Vệ quốc Vĩ đại, được phát triển để sản xuất bột mì cho các sản phẩm bánh mì và bánh kẹo.
"Cây lúa mì của chúng tôi có kích thước trung bình, với lớp rơm chắc khỏe, chống đổ ngã. Giống “Pobeda 80” được lai tạo với khả năng gieo trồng kéo dài và muộn, đến cuối tháng Mười, điều này không phải lúc nào cũng phù hợp với các giống lúa mì cổ điển", - ông Burlutsky lưu ý.
Nhà khoa học giải thích, điều này được thực hiện để khắc phục hậu quả của những tình huống phức tạp (thiên tai, điều kiện khí tượng nông nghiệp bất thường, khó khăn kinh tế), khi nông dân không thể gieo trồng theo lịch trình mùa vụ nông học.
"Giống Pobeda 80 có tỷ lệ hạt giống đem gieo lên đến 4 triệu hạt giống khỏe mạnh trên 1 hecta. Điều này đạt được nhờ sự kết hợp giữa tỷ lệ đẻ nhánh năng suất cao, khả năng sống sót của cây sau khi qua đông, khả năng chịu đựng các điều kiện bất lợi của mùa thu-đông-xuân, và khả năng cân bằng mật độ thân cây trong quá trình tỉa thưa", -ông Burlutsky giải thích.
Theo kết quả nghiên cứu trong nhiều năm quá trình sản xuất sinh thái giống lúa mì mới tại các vùng Matxcơva, Kaluga, Tula và Oryol, có sử dụng các kỹ thuật
nông nghiệp hiện đại, các nhà khoa học báo cáo rằng năng suất đạt tới 120 c/ha.
20 Tháng Mười 2025, 17:17
Bông hoa lúa mì có hàm lượng hạt cao—80% hoặc hơn. Khi chín, hạt to, căng mọng, đầy đặn (trọng lượng 1.000 hạt và trọng lượng riêng của hạt cao vì nó chứa nhiều protein và tinh bột, do đó có giá trị dinh dưỡng cao), và đồng đều (các hạt có kích thước và hình dạng đồng đều), theo báo cáo của Đại học RUDN.
Giống lúa mì này có đặc điểm là bông hoa lúa mì màu trắng, không râu, không lông và hạt cứng, màu đỏ, trong suốt, đặc trưng của giống lúa mì Erythrospermum. Hạt lúa mì "Pobeda 80" chứa tới 16% protein và tới 30% gluten đàn hồi, chắc. Loại hạt này cho năng suất bánh mì cao. Theo Đại học RUDN, đây là nguyên liệu thô chất lượng cao để sản xuất bánh mì, mì ống và các loại bánh nướng khác.